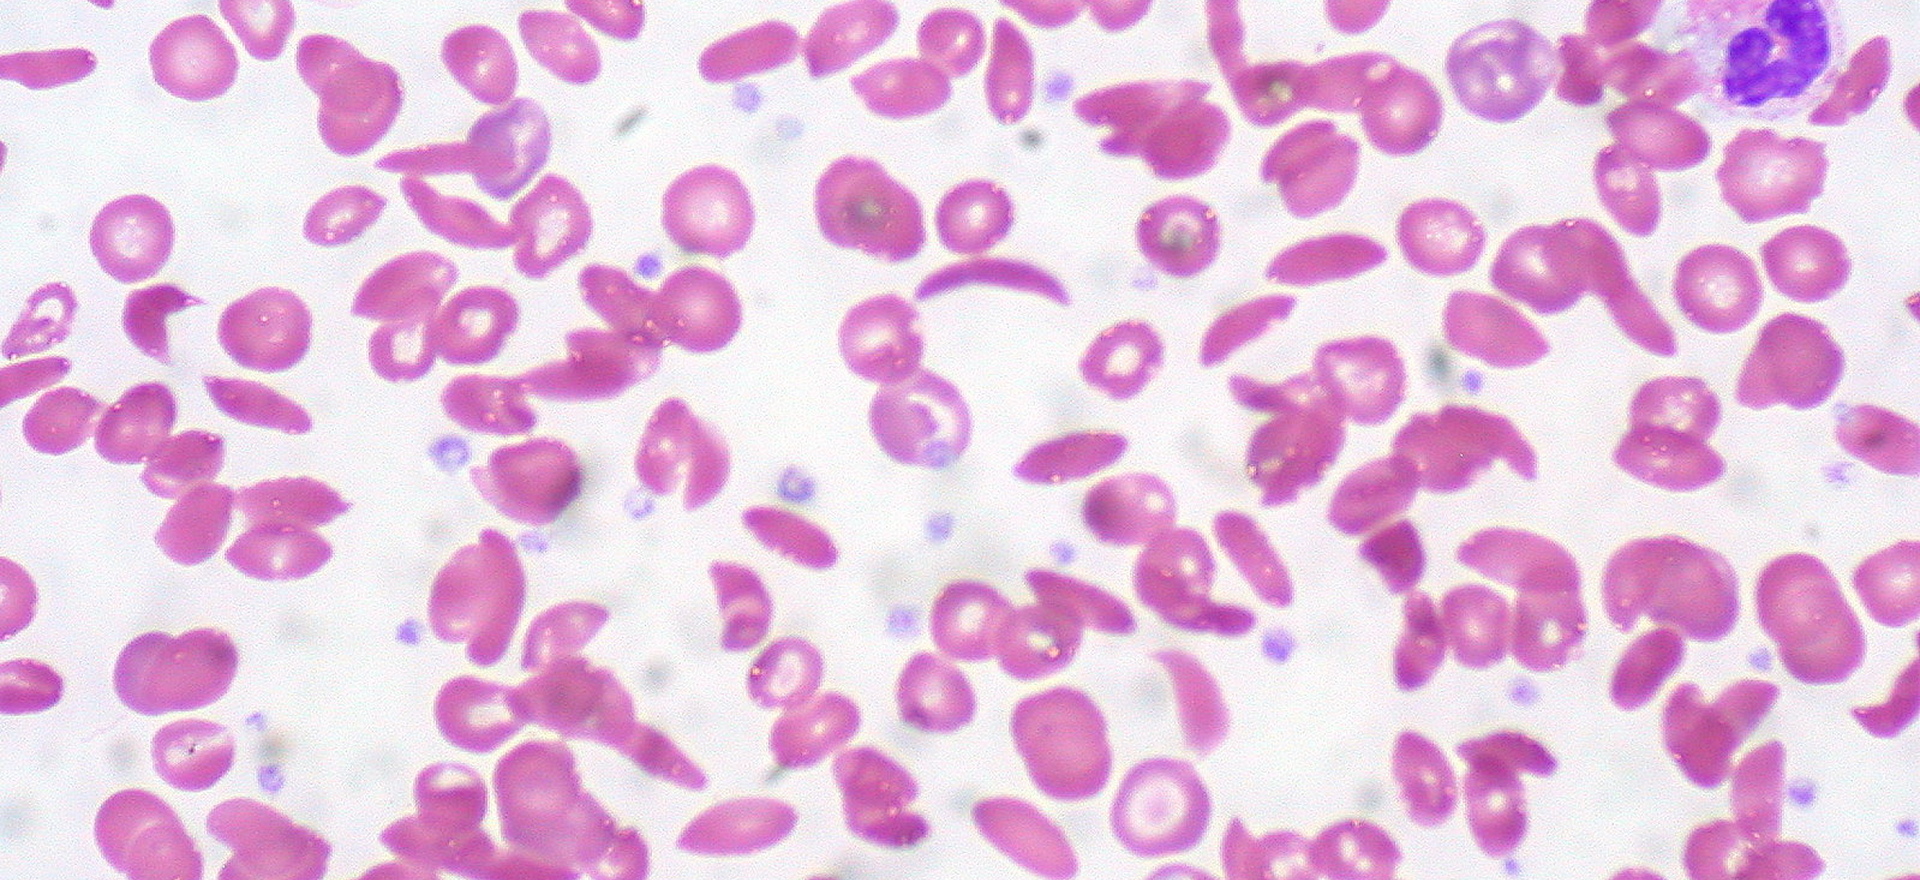

Серповидная анемия (серповидно-клеточная анемия) – это наследственное заболевание крови, которое вызывает аномальное изменение формы красных кровяных клеток (эритроцитов). Вместо нормальной круглой формы, эритроциты у людей с серповидной анемией приобретают форму полумесяца или серпа. Эти аномальные клетки не могут эффективно переносить кислород и могут блокировать кровоток, что приводит к различным осложнениям, включая болевые кризы, повреждения органов и повышенный риск инфекций.
Причины
Серповидно-клеточная анемия является генетическим заболеванием, наследуемым по аутосомно-рецессивному типу. Это значит, что для того чтобы заболевание проявилось, ребенок должен унаследовать дефектный ген от обоих родителей. Люди, у которых только один дефектный ген, считаются носителями заболевания (гетерозиготами) и обычно не имеют симптомов, но могут передавать его своим детям.
Симптомы
Симптомы серповидной анемии могут варьироваться от легких до тяжелых и включают:
- Анемия: хроническая усталость, бледность и слабость.
- Болевые кризы: внезапные, интенсивные боли в груди, животе, суставах или костях, которые происходят из-за блокировки кровотока серповидными клетками.
- Отечность рук и ног: вызвана нарушением кровообращения.
- Инфекции: повышенная восприимчивость к инфекциям из-за повреждения селезенки.
- Желтуха: пожелтение кожи и белков глаз из-за разрушения красных клеток.
- Замедленный рост и развитие у детей.
Диагностика
Диагностика серповидной анемии обычно начинается с анализа крови, который выявляет аномальные эритроциты. Для подтверждения диагноза проводится электрофорез гемоглобина, который позволяет определить тип гемоглобина в крови. Также могут использоваться генетические тесты для выявления мутации гена, ответственного за это заболевание.
Лечение
Лечение серповидной анемии направлено на облегчение симптомов и предотвращение осложнений:
- Обезболивание: при болевых кризах используются обезболивающие средства, а в тяжелых случаях — наркотические анальгетики.
- Переливание крови: иногда требуется переливание здоровых эритроцитов для улучшения кислородной доставки.
- Антибиотики и вакцинация: для профилактики инфекций.
- Пересадка костного мозга: единственное возможное лечение, которое может привести к полному излечению заболевания, но оно требует наличия подходящего донора.
Профилактика и управление рисками
- Генетическое консультирование: для пар, у которых есть риск рождения ребенка с серповидной анемией, рекомендуется генетическое консультирование для оценки вероятности передачи болезни.
- Поддерживающая терапия: регулярное наблюдение за состоянием здоровья и выполнение рекомендаций врачей могут значительно улучшить качество жизни больных.
Прогноз
Серповидная анемия — врожденное хроническое заболевание, которое может привести к различным осложнениям, включая инсульты, проблемы с органами (особенно с почками и легкими), а также инфаркты тканей и органов из-за плохого кровообращения. Однако с современным лечением и правильным уходом многие пациенты могут вести активную жизнь.
Серповидная анемия требует комплексного подхода к лечению и постоянного медицинского наблюдения. Важно, чтобы пациенты с этим заболеванием имели доступ к специализированной медицинской помощи и принимали меры для предотвращения осложнений.